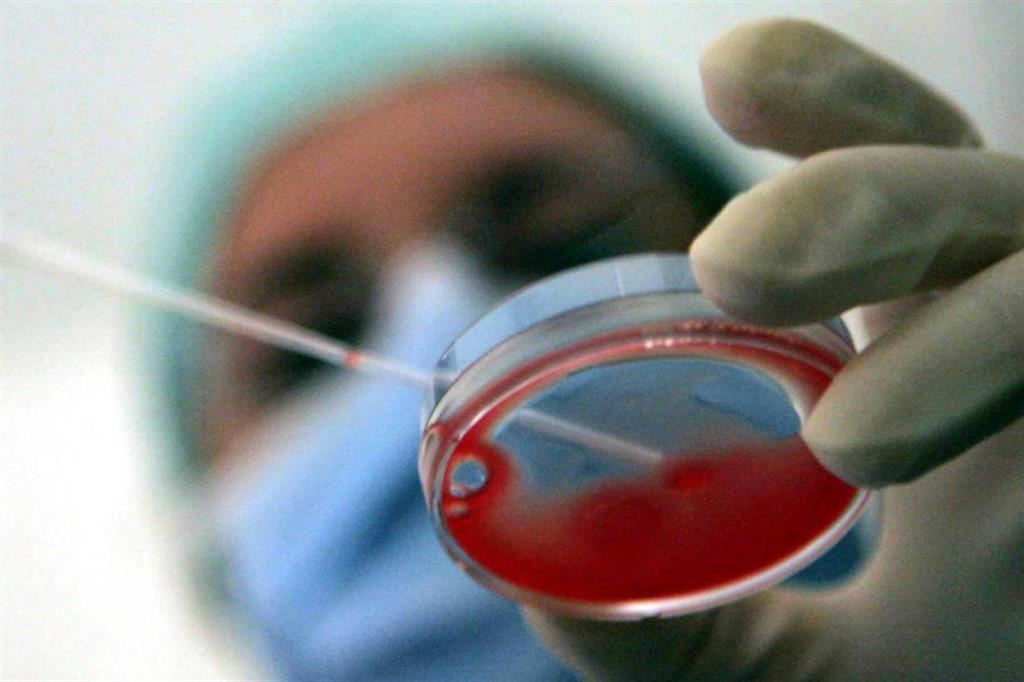

News
Avere anche un padre: perché è questo il vero “interesse del minore”
Qual è il diritto del soggetto più fragile nella fecondazione assistita?
Link copiato negli appunti
La recente decisione della Corte costituzionale sull’attribuzione dello status di genitore alla madre d’intenzione, che ha prestato il suo consenso alla fecondazione in provetta di un bambino nato dalla gravidanza della sua compagna, presenta una criticità ineludibile.



